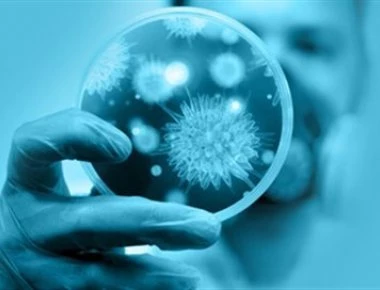
Τα πιο σημαντικά αυτοάνοσα νοσήματα - Άκρως επικίνδυνα για την υγεία

ΥΓΕΙΑ
-

Νέα έρευνα: Οι διαβητικοί κινδυνεύουν περισσότερο από Πάρκινσον
Αυξημένο κίνδυνο εκδήλωσης της νόσου Πάρκινσον αργότερα στη ζωή τους αντιμετωπίζουν οι άνθρωποι που πάσχουν από διαβήτη τύπου 2, σύμφωνα με μια νέα μεγάλη βρετανική επιστημονική μελέτη. ...
Read More » -

Ιδού γιατί δεν πρέπει να πετάτε τα κοτσάνια από τα κεράσια – Πώς να τα φάτε
Είναι γνωστό πως τα κεράσια είναι ένας διατροφικός θησαυρός που πρέπει να καταναλώνουμε τα καλοκαίρια. Γιατί τα ζουμερά κεράσια, εκτός από υπέροχη γεύση προσφέρουν και πολλά οφέλη σοτν...
Read More » -

Κρούσματα ψώρας σε αστυνομικά τμήματα λόγω μεταναστών
Τρία κρούσματα ψώρας σε διάστημα ενός μήνα σε κρατούμενους που μεταφέρθηκαν στα κρατητήρια των αστυνομικών τμημάτων του Αιγάλεω και του Μενιδίου, καθώς και στο προαναχωρησιακό κέντρο της...
Read More » -

Δείτε τις 10 ασθένειες που μπορούν να σας σκοτώσουν μέσα σε μία μέρα! (βίντεο)
Η σκέψη του να ξυπνήσετε μια μέρα χωρίς συμπτώματα και μέχρι να έρθει το άλλο πρωί να είστε στα πρόθυρα του θανάτου από κάποια ασθένεια, είναι τρομακτική, αλλά, δυστυχώς, είναι πιθανό! ...
Read More » -

Πρόληψη καρκίνου: Δώδεκα μέτρα που μπορείτε να λάβετε σήμερα κιόλας
Ο κίνδυνος εμφάνισης καρκίνου καθοδηγείται ως έναν βαθμό από γενετικούς παράγοντες, ωστόσο ο Παγκόσμιος Οργανισμός Υγείας εκτιμά ότι τουλάχιστον ένα στα τρία περιστατικά καρκίνου οφείλεται σε τροποποι...
Read More » -

Οι τρόποι μετάδοσης του ιού HPV – Πως μπορούμε να προστατευτούμε
Ο ιός των ανθρωπίνων θηλωμάτων (Human Papilloma Virus – HPV) διαθέτει την ιδιότητα να πολλαπλασιάζεται στις επιφάνειες του ανθρωπίνου σώματος και μερικές φορές να προξενεί ποικίλες βλάβε...
Read More » -

Πίνετε μπύρες; Τότε θα πρέπει να διαβάσετε αυτό! Σας ενδιαφέρει 100%
Όσες περισσότερες μπύρες πίνει κανείς μαζεμένες, τόσο αυξάνει ο κίνδυνος αρρυθμίας της καρδιάς, σύμφωνα με μια νέα γερμανική επιστημονική έρευνα. Οι ερευνητές, με επικεφαλής τους επίκο...
Read More » -

Σε ποια τρόφιμα δεν πρέπει να χρησιμοποιούμε αλουμινόχαρτο
Το αλουμινόχαρτο αποτελεί αναπόσπαστο κομμάτι της λίστας για τα ψώνια μας, καθώς μπορούμε να το χρησιμοποιήσουμε με ποικίλους τρόπους για να προστατεύσουμε τα τρόφιμά μας και να τα διατη...
Read More » -
Τα πιο σημαντικά αυτοάνοσα νοσήματα - Άκρως επικίνδυνα για την υγεία
Τα αυτοάνοσα νοσήματα, όπως υποδηλώνει άλλωστε και το όνομά τους, οφείλονται σε δυσλειτουργία του ανοσοποιητικού συστήματος. Συγκεκριμένα, εκδηλώνονται όταν αυτό επιτίθεται σε ιστούς του σώματος, ενώ ...
Read More » -

Διεγνώσθη με καρκίνο στα μάτια - Η αιτία που τον προκάλεσε; Κάτι που κάνουμε κάθε βράδυ!
Μια καθημερινή συνήθεια δημιούργησε σοβαρό πρόβλημα σε έναν Ιάπωνα. Ο 40χρονος άντρας πήγε στον γιατρό γιατί δεν έβλεπε καλά, ενώ τα μάτια του είχαν κοκκινήσει. Δεν φανταζόταν όμως τη δυσάρεστη έκπληξ...
Read More »
